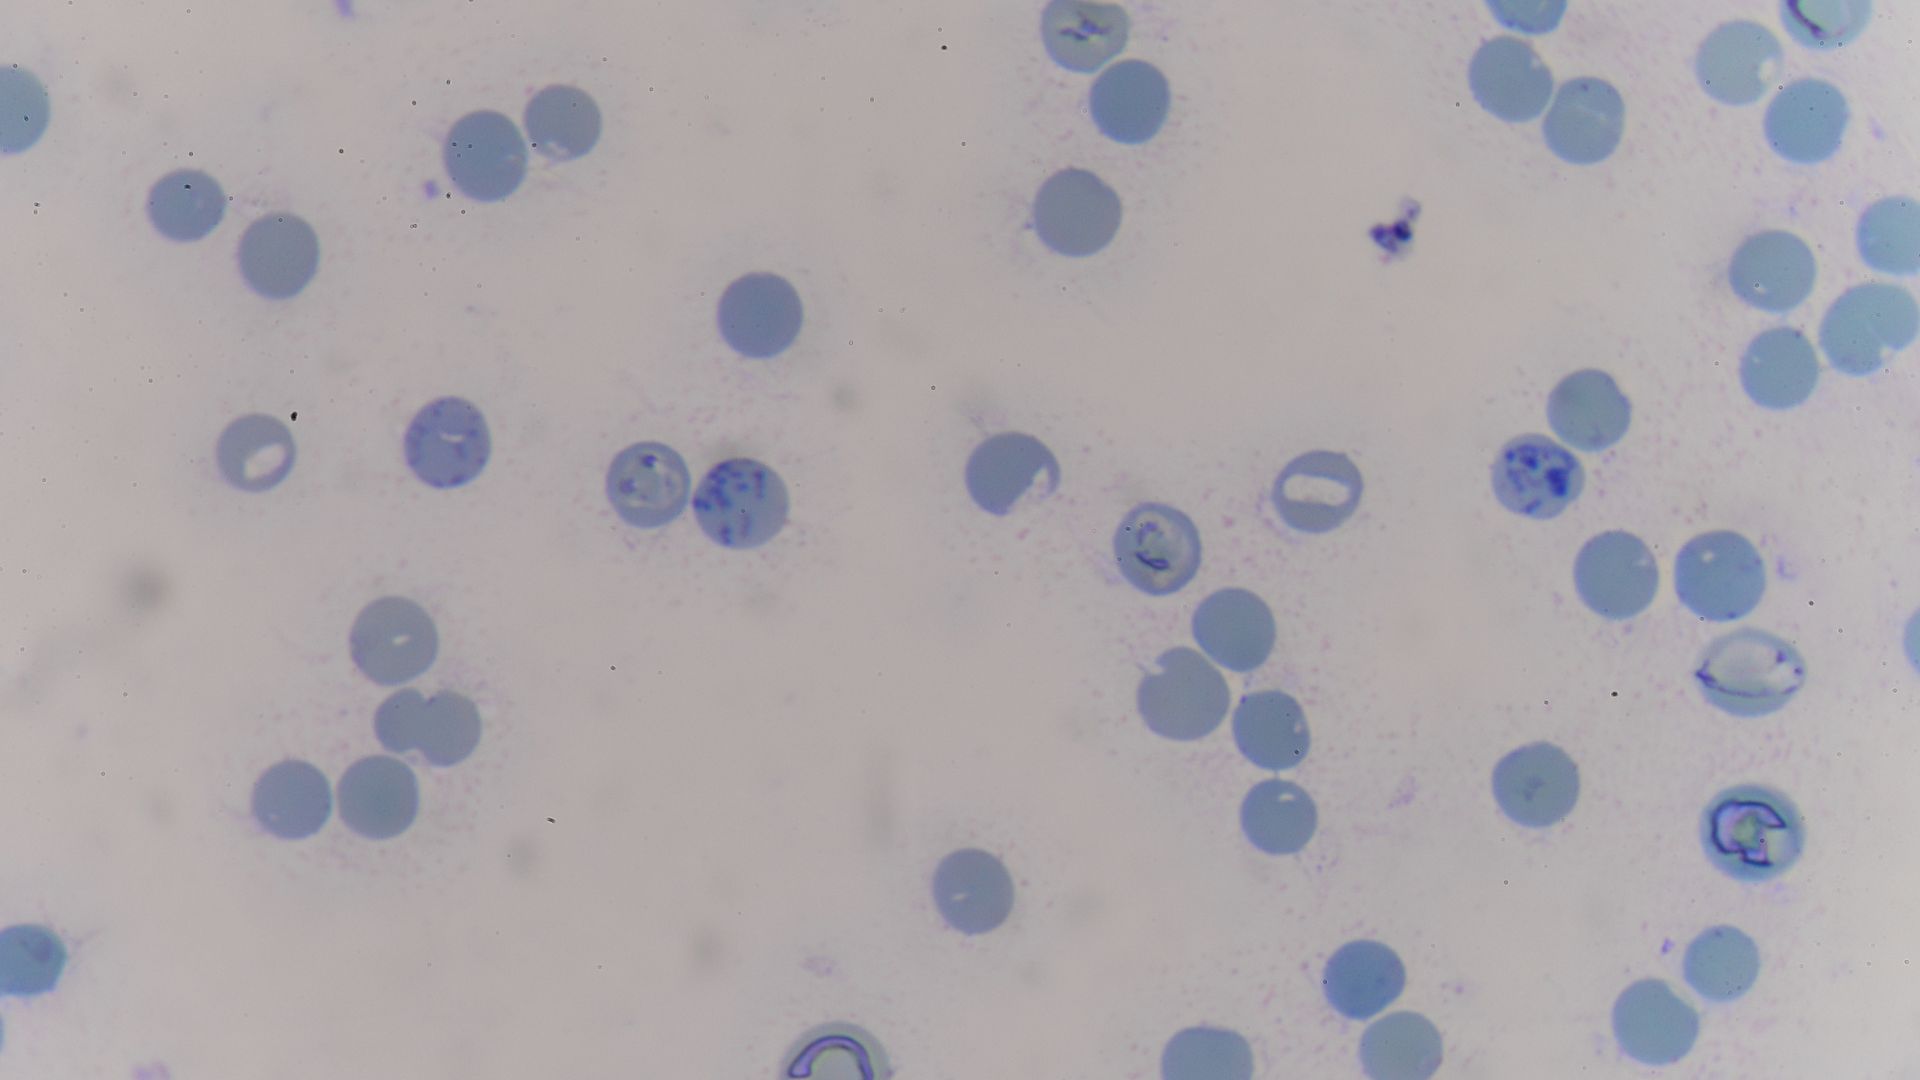
Bác sĩ thường kết hợp song song xét nghiệm nồng độ Haptoglobin và hồng cầu lưới trong chẩn đoán và theo dõi tiến triển bệnh

Việc hiểu đúng về xét nghiệm đo nồng độ Haptoglobin đóng vai trò quan trọng trong hỗ trợ bác sĩ đưa ra quyết định chẩn đoán và điều trị chính xác, đồng thời giúp người bệnh tiếp cận thông tin y khoa một cách khoa học và đáng tin cậy. Hãy cùng bài viết dưới đây tìm hiểu rõ hơn về định lượng Haptoglobin cũng như quy trình thực hiện xét nghiệm như thế nào nhé!
Định lượng Haptoglobin là gì?
Xét nghiệm đo nồng độ Haptoglobin trong huyết thanh là một trong những công cụ cận lâm sàng quan trọng, thường được chỉ định trong chẩn đoán và theo dõi các bệnh lý huyết học và viêm. Haptoglobin là một glycoprotein do gan sản xuất, có chức năng gắn kết với hemoglobin tự do được giải phóng vào máu khi các tế bào hồng cầu bị phá vỡ, từ đó ngăn chặn các tổn thương do quá trình oxy hóa và hỗ trợ loại bỏ hemoglobin ra khỏi tuần hoàn. Việc đo nồng độ Haptoglobin giúp xác định có hay không có sự hiện diện của tình trạng tan máu nội mạch, đồng thời là chỉ dấu hỗ trợ phân biệt các nguyên nhân khác nhau gây thiếu máu.

Ngoài ra, nồng độ Haptoglobin cũng có thể thay đổi trong nhiều tình trạng khác như viêm cấp, bệnh lý gan hoặc chấn thương mô. Với độ nhạy và tính đặc hiệu tương đối cao, xét nghiệm định lượng Haptoglobin mang lại giá trị thực tiễn trong lâm sàng khi được kết hợp với các xét nghiệm bổ sung khác. Do đó, hiểu rõ mục đích và cách diễn giải kết quả sẽ giúp nâng cao hiệu quả điều trị và theo dõi sức khỏe bệnh nhân.
Vai trò của Haptoglobin trong chẩn đoán thiếu máu tan máu
Haptoglobin là một chỉ dấu sinh học có giá trị trong lâm sàng, đặc biệt khi đánh giá các trường hợp nghi ngờ thiếu máu tan máu. Việc hiểu rõ cơ chế hoạt động và ý nghĩa của chỉ số này giúp bác sĩ nhận diện đúng nguyên nhân gây thiếu máu và đưa ra hướng xử trí phù hợp hơn. Một số vai trò của Haptoglobin trong chẩn đoán thiếu máu tan máu có thể kể đến như:
Haptoglobin giúp phát hiện tình trạng tan máu nội mạch
Trong thiếu máu tan máu, hồng cầu bị phá vỡ sớm hơn bình thường và giải phóng hemoglobin vào huyết tương. Haptoglobin có nhiệm vụ “bắt giữ” hemoglobin tự do để hạn chế độc tính và hỗ trợ cơ thể đào thải. Vì vậy, khi tan máu nội mạch xảy ra mạnh, Haptoglobin sẽ bị tiêu thụ nhanh, dẫn đến nồng độ giảm rõ rệt.

Haptoglobin hỗ trợ phân biệt các nguyên nhân thiếu máu
Thiếu máu có thể do thiếu sắt, mất máu, bệnh mạn tính hoặc tan máu. Trong đó, giảm Haptoglobin là dấu hiệu gợi ý mạnh cho nhóm nguyên nhân tan máu, đặc biệt khi đi kèm các biểu hiện như vàng da nhẹ, nước tiểu sẫm màu hoặc mệt mỏi kéo dài. Điều này giúp bác sĩ thu hẹp chẩn đoán và lựa chọn hướng xét nghiệm phù hợp.
Kết hợp với các chỉ số khác để tăng độ chính xác
Haptoglobin không nên dùng đơn lẻ. Trên thực tế, bác sĩ thường đánh giá song song với LDH, bilirubin gián tiếp, hồng cầu lưới và soi máu ngoại biên. Khi các chỉ số này cùng hướng về tan máu, kết quả Haptoglobin sẽ trở thành bằng chứng hỗ trợ rất giá trị trong chẩn đoán và theo dõi tiến triển bệnh.
Quy trình xét nghiệm định lượng Haptoglobin
Xét nghiệm đo nồng độ Haptoglobin là một kỹ thuật sinh hóa được thực hiện trên mẫu máu nhằm đánh giá sự hiện diện hoặc mức độ nghi ngờ tan máu trong cơ thể. Dưới đây là quy trình thực hiện xét nghiệm này theo các bước cụ thể:
- Chỉ định xét nghiệm: Được thực hiện khi bệnh nhân có dấu hiệu nghi ngờ tan máu như vàng da nhẹ, nước tiểu sẫm, thiếu máu không rõ nguyên nhân. Thường đi kèm các xét nghiệm khác như LDH, bilirubin hoặc hồng cầu lưới.
- Lấy mẫu máu: Máu tĩnh mạch được lấy bằng kim tiêm vô trùng. Mẫu máu thường được thu vào ống chứa chất chống đông phù hợp hoặc ống không có chất chống đông tùy thuộc vào phương pháp phân tích tại phòng xét nghiệm.
- Xử lý và phân tích mẫu: Mẫu máu được ly tâm để tách huyết thanh hoặc huyết tương. Phân tích được thực hiện bằng kỹ thuật miễn dịch định lượng hoặc đo quang phổ trên hệ thống máy xét nghiệm tự động.
- Trả kết quả và diễn giải: Kết quả thường có sau vài giờ đến một ngày tùy cơ sở. Giá trị Haptoglobin được so sánh với mức tham chiếu để xác định tăng, giảm hay bình thường. Bác sĩ sẽ kết hợp với lâm sàng và các xét nghiệm khác để đưa ra chẩn đoán chính xác.

Các yếu tố ảnh hưởng đến nồng độ Haptoglobin
Nồng độ Haptoglobin trong huyết thanh không chỉ phản ánh tình trạng tan máu, mà còn có thể bị ảnh hưởng bởi nhiều yếu tố nội tại và bệnh lý đi kèm. Việc hiểu rõ các yếu tố này giúp bác sĩ tránh chẩn đoán sai lệch và nâng cao độ chính xác trong đánh giá kết quả xét nghiệm. Cụ thể:
Tình trạng tan máu nội mạch
Đây là yếu tố ảnh hưởng rõ rệt nhất đến nồng độ Haptoglobin. Khi các tế bào hồng cầu bị phá hủy trong lòng mạch, hemoglobin tự do sẽ xuất hiện nhiều trong huyết tương. Haptoglobin được huy động để gắn kết và trung hòa hemoglobin này, dẫn đến sự suy giảm nhanh chóng nồng độ Haptoglobin, đặc biệt trong các bệnh lý như thiếu máu tan máu tự miễn, phản ứng truyền máu không tương thích hoặc tan máu do nhiễm khuẩn.

Tình trạng viêm cấp và stress sinh lý
Haptoglobin là một protein pha cấp vì vậy nồng độ của nó có thể tăng cao trong các phản ứng viêm cấp tính như viêm phổi, viêm ruột, chấn thương nặng hoặc sau phẫu thuật. Trong các trường hợp này, gan được kích thích sản xuất nhiều Haptoglobin hơn như một phần của phản ứng viêm hệ thống. Điều này có thể che lấp dấu hiệu của tan máu nhẹ, nếu chỉ dựa vào chỉ số đơn lẻ này.
Bệnh lý gan và chức năng gan suy giảm
Gan là nơi tổng hợp chính của Haptoglobin do đó bệnh lý gan mạn tính như xơ gan, viêm gan siêu vi, ung thư gan có thể làm giảm sản xuất Haptoglobin, dẫn đến nồng độ huyết thanh thấp mặc dù không có tan máu. Trường hợp này rất dễ gây hiểu nhầm nếu không kết hợp với xét nghiệm men gan và các chỉ dấu chức năng gan khác.

Sử dụng thuốc và tình trạng cơ thể
Một số loại thuốc như corticosteroids, androgen hoặc thuốc kháng viêm không steroid (NSAIDs) có thể làm tăng nồng độ Haptoglobin giả tạo. Ngược lại, người có dinh dưỡng kém, suy nhược kéo dài hoặc mắc bệnh mạn tính cũng có thể có mức Haptoglobin thấp.
Như vậy có thể thấy, xét nghiệm định lượng Haptoglobin là một công cụ quan trọng trong thực hành lâm sàng, đặc biệt trong chẩn đoán thiếu máu tan máu và đánh giá phản ứng viêm. Tuy không phải là xét nghiệm phổ quát trong mọi tình huống, nhưng khi được sử dụng đúng chỉ định và phân tích hợp lý, nó góp phần nâng cao hiệu quả điều trị và theo dõi bệnh nhân. Để đảm bảo độ chính xác, xét nghiệm này cần được kết hợp với nhiều chỉ dấu sinh học khác và nên được giải thích bởi bác sĩ chuyên môn.
:format(webp)/Desktop_da87817305.png)
:format(webp)/Mobile_1_0b0c1a773a.png)
/xet_nghiem_erythropoietin_la_gi_1_9a43964313.png)
/cach_hieu_dinh_luong_glucose_mau_va_cham_soc_suc_khoe_duong_huyet_4_4a31919395.png)
/chi_so_dan_hoi_mo_gan_f0_1_la_gi_muc_do_nguy_hiem_va_cach_bao_ve_gan_42c2fb402f.jpg)
/xet_nghiem_ung_thu_vom_hong_gom_nhung_gi_va_khi_nao_can_thuc_hien_1_3758cd2011.png)
/men_gan_cao_1500_co_nguy_hiem_khong_nguyen_nhan_gay_tang_men_gan_dot_ngot_4_f869e7f029.png)